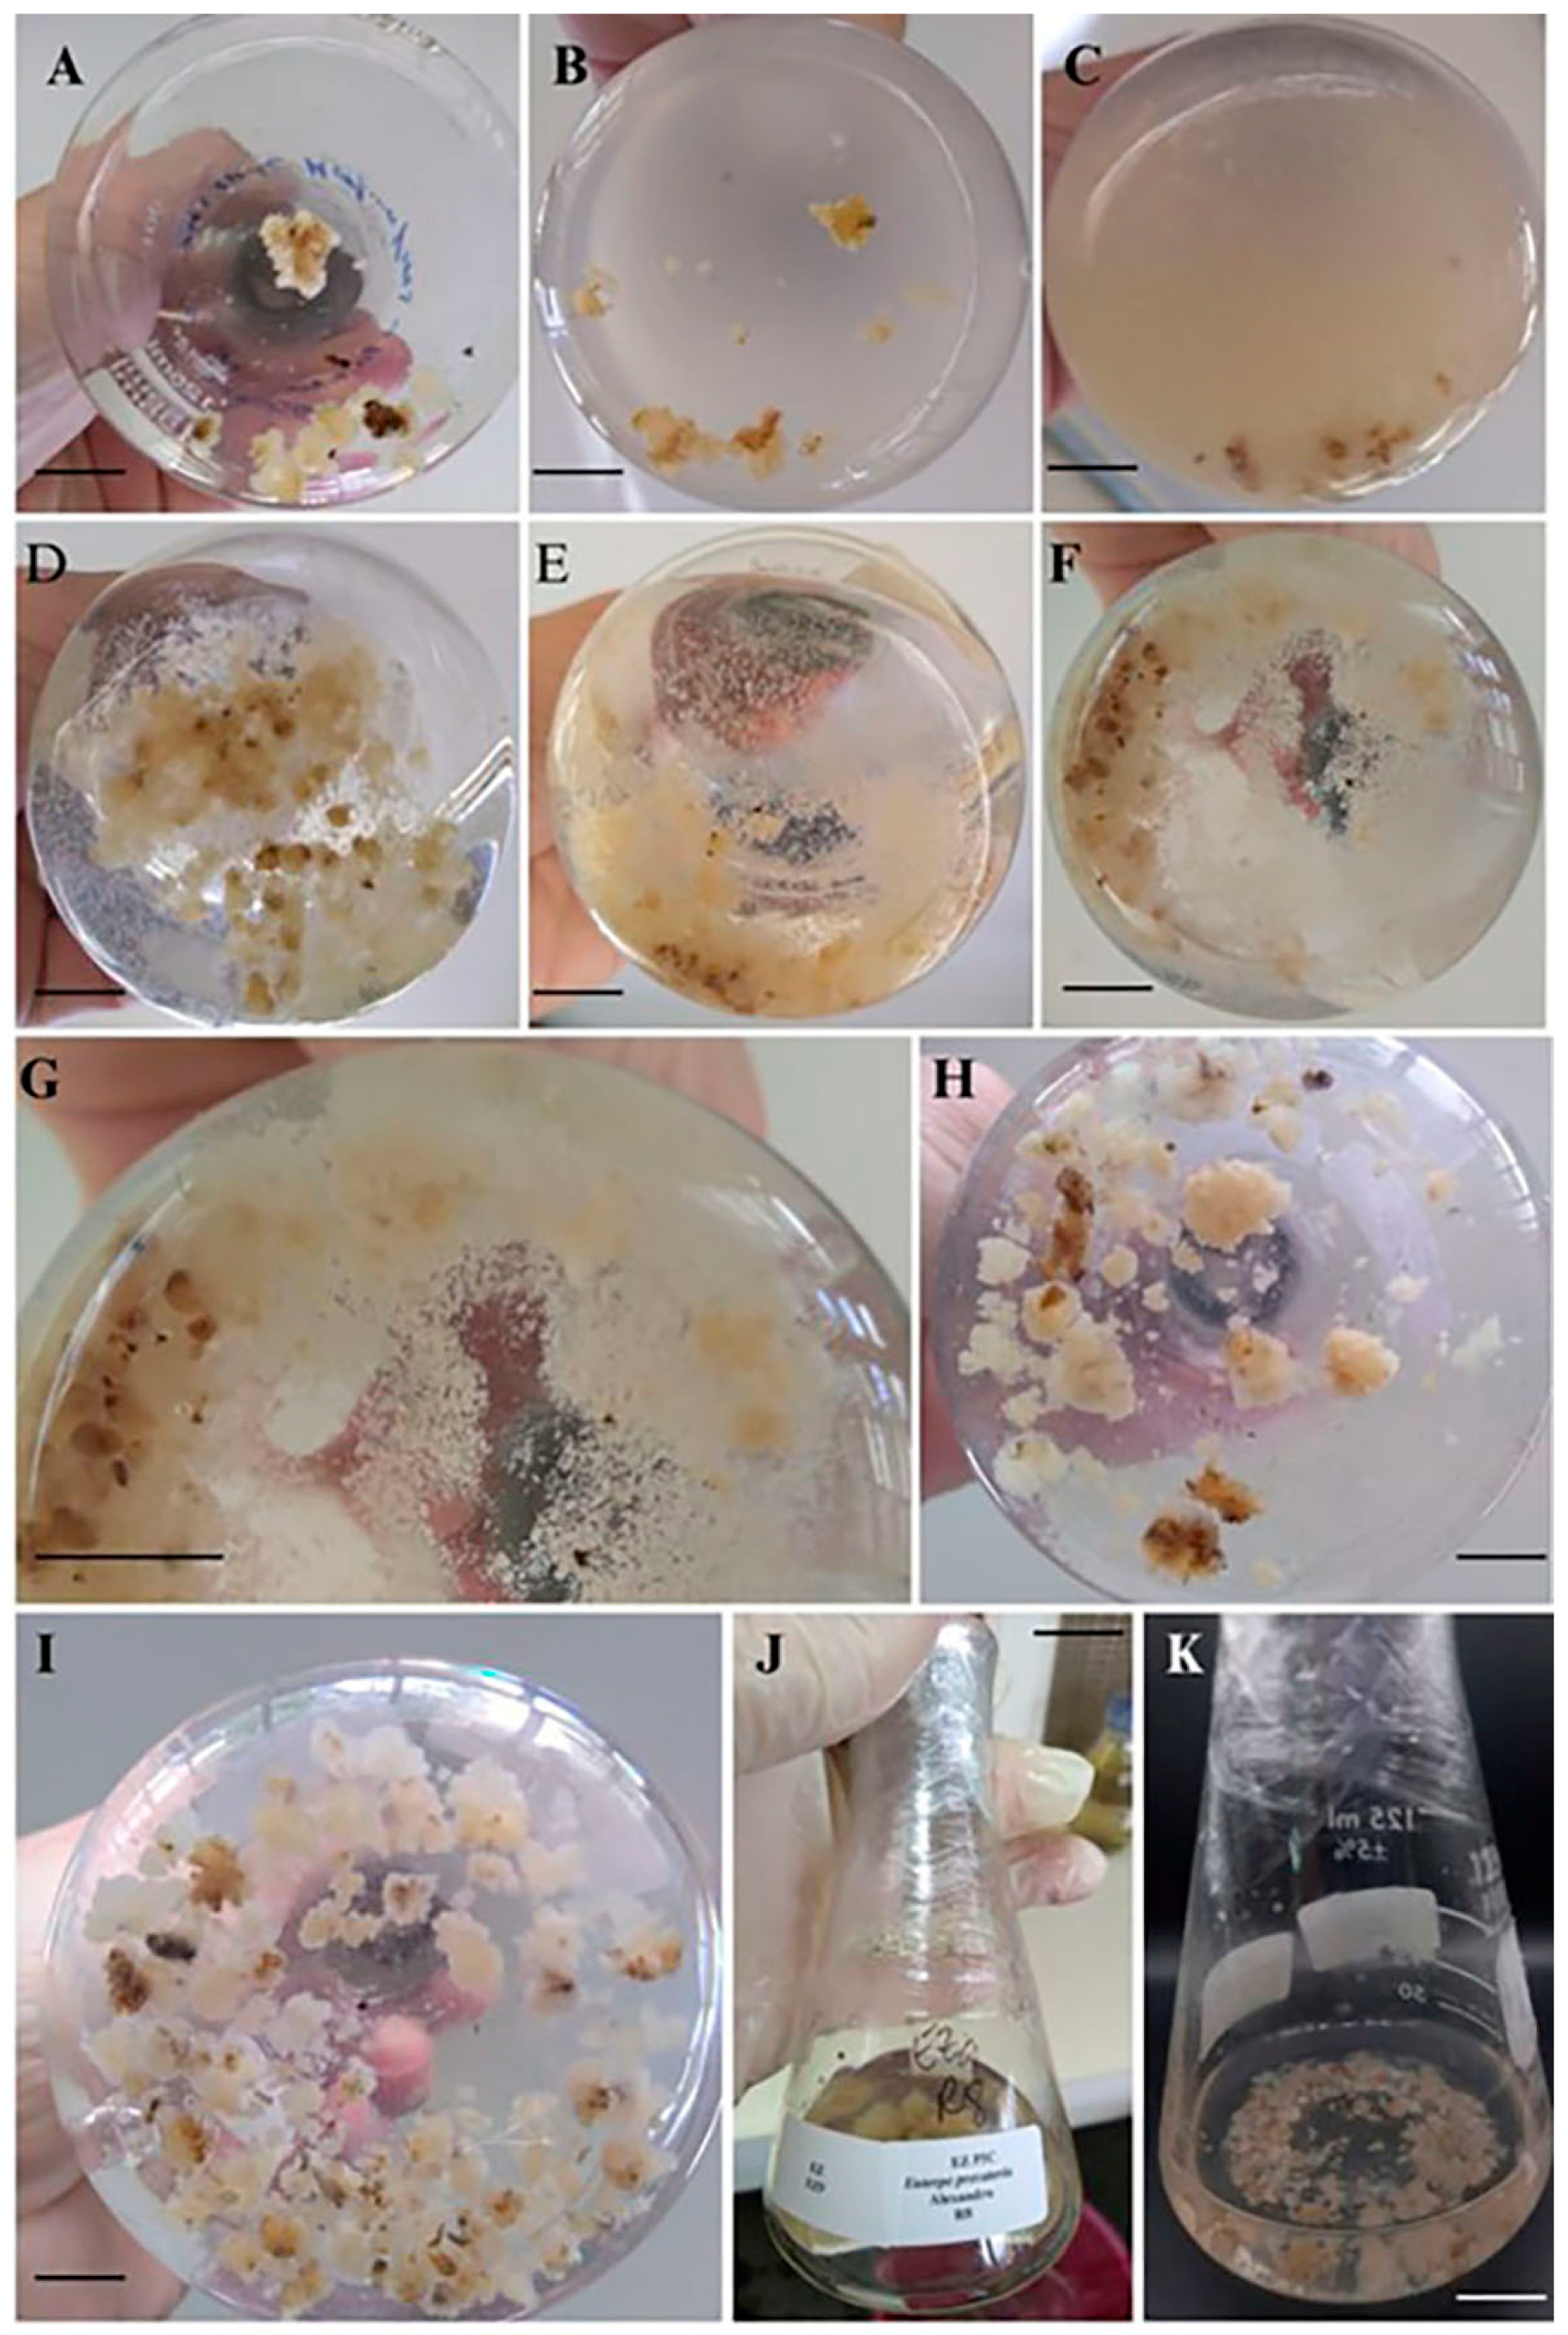
Forests 15 01804 g004 Forests 15 01804 g004

Establishment, Multiplication, and Biochemical Analysis of Embryogenic Lines of the Amazonian Palm Euterpe precatoria Mart. under Suspension Culture
Abstract
1. Introduction
2. Materials and Methods
2.1. Plant Material, Induction, and Multiplication of Embryogenic Callus in Semisolid Medium
2.1.1. Induction and Multiplication of Leaf Explant Calli
2.1.2. Induction and Multiplication of Inflorescence Explant Calli
2.1.3. Induction and Multiplication of Zygotic Embryo Explant Calli
2.2. Weighing of Embryogenic Calluses in Semisolid Medium
2.3. Establishment and Multiplication of Embryogenic Calluses in Liquid Medium
2.4. Characterization of Lineages
2.5. Design and Statistical Analysis of Weighing Semisolid Medium vs. Liquid Medium
2.5.1. Gompertz Modeling
2.5.2. Kinetic Parameters
2.5.3. Principal Component Analysis (PCA)
2.6. Biochemical Characterization
2.6.1. Total Soluble Sugars (TSSs)
2.6.2. Total Soluble Proteins (TSPs)
2.7. Anatomical Characterization
3. Results
3.1. Initial Establishment of Calli in Liquid Medium and Multiplication of Aggregates and Cells in Suspension
3.2. Growth Kinetics of Cellular Aggregates and Application of the Gompertz Mathematical Model
3.3. Principal Component Analysis (PCA)
3.4. Biochemical Characterization and Levels of Total Soluble Proteins (TSPs) and Total Soluble Sugars (TSSs) of E. precatoria
3.5. Anatomical Analysis
4. Discussion
4.1. Establishment of Calli in Liquid Medium and Multiplication of Embryogenic Aggregates in Suspension
4.2. Gompertz and Growth Kinetics
4.3. Growth Correlations among Lineages Evaluated by Principal Component Analysis
4.4. Biochemical Analysis
4.5. Anatomical Analysis
5. Conclusions
Author Contributions
Funding
Data Availability Statement
Acknowledgments
Conflicts of Interest
References
- Baker, W.; Norup, M.V.; Clarkson, J.J.; Couvreur, T.L.P.; Dowe, J.L.; Lewis, C.E.; Pintaud, J.-C.; Savolainen, V.; Wilmot, T.; Chase, M.W. Phylogenetic relationships among arecoid palms (Arecaceae: Arecoidae). Ann. Bot. 2011, 108, 1417–1432. [Google Scholar] [CrossRef] [PubMed]
- Ferreira, C.D.; Silva-Cardoso, I.M.A.; Ferreira, J.C.B.; Costa, F.H.S.; Scherwinski-Pereira, J.E. Morphostructural and histochemical dynamics of Euterpe precatoria (Arecaceae) germination. J. Plant Res. 2020, 133, 693–713. [Google Scholar] [CrossRef] [PubMed]
- Melo, G.S.; Souza, F.C.; Silva, L.C. O cenário da produção do açaí (Euterpe spp.) no estado do Amazonas. Braz. J. Dev. 2021, 7, 71536–71549. [Google Scholar] [CrossRef]
- Oliveira, J.F.; Ferreira, A.C.; Freitas, H.F.; Raghiante, F.; Biondi, G.F.; Martins, O.A. Análises físico-química e microbiológica de palmito em conserva do tipo Açaí (Euterpe oleracea). Rev. Bras. Hig. Sanidade Anim. 2017, 11, 8–18. [Google Scholar]
- Santos, M.R.A.; Rocha, J.F.; Ferreira, M.G.R.; Correira, A.O. Estabelecimento in vitro e calogênese em explantes foliares de pupunheira. Rev. Cienc. Agrar. 2012, 55, 197–203. [Google Scholar] [CrossRef]
- Gordon, A.; Cruz, A.P.G.; Cabral, L.M.C.; Freitas, S.C.; Taxi, C.M.A.D.; Donangelo, C.M. Chemical characterization and evaluation of antioxidante properties of acai fruits (Euterpe oleracea Mart.) during ripening. Food Chem. 2012, 133, 256–263. [Google Scholar] [CrossRef] [PubMed]
- Ferreira, D.S.; Gomes, A.L.; Silva, M.G.; Alves, A.B.; Agnol, W.H.D.; Ferrari, R.A.; Pacheco, M.T.B. Antioxidant capacity and chemical characterization of açaí (Euterpe oleracea Mart.) fruit fractions. J. Food Sci. Technol. 2016, 4, 95–102. [Google Scholar] [CrossRef]
- Lisboa, C.R.; Oliveira, M.S.P.; Chisté, R.C.; Carvalho, A.V. Bioactive compounds and antioxidant potential of different accessions of Euterpe oleracea and Euterpe precatoria from the active açaí germoplasm bank. Res. Soc. Dev. 2022, 11, e428111234824. [Google Scholar] [CrossRef]
- Oliveira, M.S.P.; Mattietto, R.A.; Domingues, A.F.N.; Carvalho, A.C.; Oliveira, N.P.; Farias Neto, J.T. Euterpe oleracea e E. precatoria, Açaí. In Espécies Nativas da Flora Brasileira de Valor Econômico Atual ou Potencial: Plantas Para o Futuro: Região Norte; Coradin, L., Camillo, J., Vieira, I.C.G., Eds.; MMA: Brasília, Brazil, 2022; pp. 303–323. [Google Scholar]
- IBGE. Produção de Açaí. Available online: https://www.ibge.gov.br/explica/producao-agropecuaria/acai-cultivo/br (accessed on 20 May 2024).
- Ramos, S.L.F.; Dequigiovanni, G.; Lopes, M.T.G.; Aguiar, A.V.; Lopes, R.; Veasey, E.A.; Macedo, J.L.V.; Alves-Pereira, A.; Fraxe, T.J.P.; Wrege, M.S.; et al. Genetic structure in populations of Euterpe precatoria Mart. in the Brazilian Amazon. Front. Ecol. Evol. 2021, 8, 603448. [Google Scholar] [CrossRef]
- Ferreira, J.C.B.; Silva-Cardoso, I.M.A.; Meira, R.O.; Scherwinski Pereira, J.E. Somatic embryogenesis and plant regeneration from zygotic embryos of the palm tree Euterpe precatoria Mart. Plant Cell Tissue Organ Cult. 2022, 148, 667–686. [Google Scholar] [CrossRef]
- Ferreira, J.C.B.; Silva-Cardoso, I.M.A.; Meira, R.O.; Scherwinski Pereira, J.E. Towards development of an efficient somatic embryogenesis protocol for the palm tree Euterpe precatoria (Mart.) from leaf tissues of adult plants. Vitr. Cell. Dev. Biol.-Plant 2022, 58, 750–768. [Google Scholar] [CrossRef]
- Silva, I.M.A.; Scherwinski-Pereira, J.E. Somatic embryogenesis as a tool for propagation of palm trees (Arecaceae): Principles, strategies and challenges. In Micropropagation of Ornamental Plants; Bettaieb, T., Ed.; Nova Science Publishers: New York, NY, USA, 2018; pp. 139–194. [Google Scholar]
- Monteiro, T.R.; Freitas, E.O.; Nogueira, G.F.; Scherwinski-Pereira, J.E. Assessing the influence of subcultures and liquid medium during somatic embryogenesis and plant regeneration in oil palm (Elaeis guineensis Jacq.). J. Hortic. Sci. Biotechnol. 2018, 93, 196–203. [Google Scholar] [CrossRef]
- Gomes, H.T.; Bartos, P.M.C.; Balzon, T.A.; Scherwinski-Pereira, J.E. Regeneration of somatic embryos of oil palm (Elaeis guineensis) using temporary immersion bioreactors. Ind. Crops Prod. 2016, 89, 244–249. [Google Scholar] [CrossRef]
- Naik, M.P.; Al-Khayri, J.M. Somatic Embryogenesis of date palm (Phoenix dactylifera L.) through cell suspension culture. Methods Mol. Biol. 2016, 1391, 357–366. [Google Scholar] [CrossRef]
- Naik, P.M.; Al-Khayri, L.M. Cell suspension culture as a means to produce polyphenols from date palm (Phoenix dactylifera L.). Ciência Agrotecnologia 2018, 42, 464–473. [Google Scholar] [CrossRef]
- Abohatem, M.A.; Bakil, Y.; Baaziz, M. Plant regeneration from somatic embryogenic suspension cultures of date palm. In Date Palm Biotechnology Protocols. Tissue Culture Applications; Al-Khayri, J.M., Jain, S.M., Johnson, D.V., Eds.; Humana Press: New York, NY, USA, 2017; Volume 1, pp. 203–214. [Google Scholar] [CrossRef]
- Ferreira, J.C.B. Embriogênese Somática de Açaí Solteiro (Euterpe precatoria Mart.). Ph.D. Thesis, Universidade de Brasília, Brasília, Brazil, 2020. [Google Scholar]
- Murashige, T.; Skoog, F. A revised medium for rapid growth and bioassays with tobacco tissue cultures. Physiol. Plant. 1962, 15, 473–497. [Google Scholar] [CrossRef]
- Eeuwens, C.J. Mineral requirements for growth and callus initiation of tissue explants Excised from mature coconut palms (Cocos nucifera) and cultured in vitro. Physiol. Plant. 1976, 36, 23–28. [Google Scholar] [CrossRef]
- Ferreira, D.F. SISVAR: A computer analysis system to fixed effects split plot type designs. Braz. J. Biom. 2019, 37, 529–535. [Google Scholar] [CrossRef]
- Gomes, H.T.; Bartos, P.M.C.; Silva, C.O.; Amaral, L.I.V.; Scherwinski-Pereira, J.E. Comparative biochemical profiling during the stages of acquisition and development of somatic embryogenesis in African oil palm (Elaeis guineensis Jacq.). Plant Growth Regul. 2014, 74, 199–208. [Google Scholar] [CrossRef]
- Dubois, M.; Gilles, K.A.; Hamilton, J.K.; Rebers, P.T.; Smith, F. Colorimetric method for determination of sugars and related substances. Anal. Chem. 1956, 28, 350–356. [Google Scholar] [CrossRef]
- Silva-Cardoso, I.M.A.; Meira, F.S.; Gomes, A.C.M.M.; Scherwinski-Pereira, J.E. Histology, histochemistry and ultrastructure of pre-embryogenic cells determined for direct somatic embryogenesis in the palm tree Syagrus oleracea. Physiol. Plant. 2020, 168, 845–875. [Google Scholar] [CrossRef]
- Mustafa, N.R.; Winter, W.; Van Iren, F.; Verpoorte, R. Initiation, growth and cryopreservation of plant cell suspension cultures. Nat. Protoc. 2011, 6, 715–742. [Google Scholar] [CrossRef]
- Bhatia, S. Plant tissue culture. In Modern Applications of Plant Biotechnology in Pharmaceutical Sciences, 1st ed.; Bhatia, S., Sharma, K., Dahiya, R., Bera, T., Eds.; Academic Press: Boston, MA, USA, 2015; pp. 31–107. [Google Scholar] [CrossRef]
- Ling, A.P.K.; Halmi, M.I.E.; Hussein, S.; Ong, S.L. Modelling the effect of 2–4, D on the growth kinetics of cell suspension cultures of Ficus deltoidea L. J. Biochem. Microbiol. Biotechnol. 2015, 3, 1–5. [Google Scholar] [CrossRef]
- Jamil, S.Z.M.R.; Rohani, E.R.; Baharum, S.N.; Noor, N.M. Metabolite profiles of callus and cell suspension cultures of mangosteen. 3 Biotech 2018, 8, 322. [Google Scholar] [CrossRef]
- Hua, M.; Hua, Z.; Dua, L.; Du, J.; Luo, Q.; Xiong, J. Establishment of cell suspension culture of Lonicera japonica Thunb and analysis its major secondary metabolites. Ind. Crops Prod. 2019, 137, 98–104. [Google Scholar] [CrossRef]
- Songserm, P.; Klanrit, P.; Klanrit, P.; Phetcharaburanin, J.; Thanonkeo, P.; Apiraksakorn, J.; Phomphrai, K.; Klanrit, P. Antioxidant and anticancer potential of bioactive compounds from Rhinacanthus nasutus cell suspension culture. Plants 2022, 11, 1994. [Google Scholar] [CrossRef]
- Al-Khayri, J.M. Determination of the date palm cell suspension growth curve, optimum plating efficiency, and influence of liquid medium on somatic embryogenesis. Emir. J. Food Agric. 2012, 24, 444–455. [Google Scholar]
- Guillou, C.; Fillodeau, A.; Brulard, E.; Breton, D.; Maraschin, S.F.; Verdie, D.; Simon, M.; Ducos, J.-P. Indirect somatic embryogenesis of Theobroma cacao L. in liquid medium and improvement of embryo-to-plantlet conversion rate. Vitr. Cell. Dev. Biol.-Plant 2018, 54, 377–391. [Google Scholar] [CrossRef]
- Jie, E.Y.; Ahn, M.S.; Lee, J.; Cheon, Y.I.; Kim, C.Y.; Kim, S.W. Establishment of a high-frequency plant regeneration system from rhizome-derived embryogenic cell-suspension cultures of Curcuma longa L. Plant Biotechnol. Rep. 2019, 13, 123–129. [Google Scholar] [CrossRef]
- Queiroz, F.F.; Silva-Cardoso, I.M.A.; Scherwinski-Pereira, J.E. Initiation and establishment of cell suspension cultures in bamboo. In Biotechnological Advances in Bamboo; Ahmad, Z., Ding, Y., Shahzad, A., Eds.; Springer: Singapore, 2021; pp. 107–127. [Google Scholar] [CrossRef]
- Woo, H.; Ku, S.S.; Jie, E.Y.; Kim, H.; Kim, H.-S.; Jeong, W.-J.; Park, S.U.; Min, S.R.; Kim, S.W. Efficient plant regeneration from embryogenic cell suspension cultures of Euonymus alatus. Sci. Rep. 2021, 11, 15120. [Google Scholar] [CrossRef]
- Kong, E.Y.Y.; Biddle, J.; Kalaipandian, S.; Adkins, S.W. Coconut callus initiation for cell suspension culture. Plants 2023, 12, 968. [Google Scholar] [CrossRef]
- Mazri, M.A. Role of cytokinins and physical state of the culture medium to improve in vitro shoot multiplication, rooting and acclimatization of date palm (Phoenix dactylifera L.) cv. Boufeggous. J. Plant Biochem. Biotechnol. 2015, 24, 268–275. [Google Scholar] [CrossRef]
- Panggabean, N.H.; Nurwahyuni, I.; Elimasni; Basyuni, M. Somatic embryogenesis of oil palm (Elaeis guineensis Jacq.) from bud explants using suspension culture. Online J. Biol. Sci. 2023, 23, 236–242. [Google Scholar] [CrossRef]
- Mello, T.; Silva, T.D.; Zanardo, T.É.C.; Almeida, F.A.N.; Oliveira, L.B.; Hegedus, C.E.N.; Anjos, B.B.; Schmildt, E.R.; Ferreira, A.; Ferreira, M.F.S.; et al. Somatic embryogenesis in Euterpe edulis Martius is improved by wounding, explant orientation, and suspension culture. Plant Cell Tissue Organ Cult. 2024, 156, 31. [Google Scholar] [CrossRef]
- Ramchandra, S.S.; Bhatt, P.N.; Bhatt, D.P. Callus induction and establishment of cell suspension culture of cumin (Cuminum cyminum L.). J. Plant Sci. 2020, 15, 54–63. [Google Scholar] [CrossRef]
- Mazri, M.A.; Meziani, R. Micropropagation of Date Palm: A Review. Cell Dev. Biol. 2015, 4, 1000160. [Google Scholar] [CrossRef]
- Trunjaruen, A.; Luecha, P.; Taratima, W. Optimization of medium conditions and auxins in inducing adventitious roots of pokeweed (Phytolacca americana L.) and its phytochemical constituents. Scientifica 2023, 2023, 2983812. [Google Scholar] [CrossRef] [PubMed]
- Mohamad, N.I.M.; Abdullah, T.A. Monitoring the growth of plant cells in suspension culture. In Multifaceted Protocol in Biotechnology; Amid, A., Sulaiman, S., Jimat, D., Azmin, N., Eds.; Springer: Singapore, 2018; pp. 203–214. [Google Scholar] [CrossRef]
- Aguilar-Camacho, M.; Gómez-Sánchez, C.E.; Cruz-Mendívil, A.; Guerrero-Analco, J.A.; Monribot-Villanueva, J.L.; Gutiérrez-Uribe, J.A. Modeling the growth kinetics of cell suspensions of Randia echinocarpa (Rubiaceae) and characterization of their bioactive phenolic compounds. Plant Cell Tissue Organ Cult. 2023, 155, 785–796. [Google Scholar] [CrossRef]
- Martínez, M.E.; Poirrier, P.; Prufer, D.; Schulze, G.C.; Jorquera, L.; Ferrer, P.; Díaz, K.; Chamy, R. Kinetics and modeling of cell growth for potencial anthocyanin induction in cultures of Taraxacum officinale G.H. Weber ex Wiggers (Dandelion). Electron. J. Biotechnol. 2018, 36, 15–23. [Google Scholar] [CrossRef]
- Mavituna, F.; Yoon, S.-Y.H.; Park, J.M. Modelling size distribution changes of plant cell aggregates during batch growth of Capsicum frutescens suspension culture. Chem. Eng. Sci. 2016, 148, 1–13. [Google Scholar] [CrossRef]
- Shukor, M.S.; Masdor, N.A.; Halmi, M.I.E.; Ahmad, S.A.; Shukor, M.Y. Outlier analysis of the modified Gompertz model used for modelling the growth of callus cultures from Glycine wightii (Wight & Arn.) Verdc. AJPB 2015, 3, 14–16. [Google Scholar]
- Hussein, S.; Halmi, M.I.E.; Ling, A.P.K. Modelling the growth kinetics of callus cultures from the seedling of Jatropha curcas L. according to the modified Gompertz model. JOBIMB 2016, 4, 20–23. [Google Scholar] [CrossRef]
- Hussein, S.; Shukor, M.Y. Comparison between the modified Gompertz and Churchill Death models in modelling the growth of cell culture from leaf-derived cell suspension of Barringtonia racemose. JEMAT 2017, 5, 26–29. [Google Scholar] [CrossRef]
- Bartos, P.M.C.; Gomes, H.T.; Amaral, L.I.V.; Teixeira, J.B.; Scherwinski-Pereira, J.E. Biochemical events during somatic embryogenesis in Coffea arabica L. 3 Biotech 2018, 8, 209. [Google Scholar] [CrossRef]
- Santos, D.N.; Nunes, C.F.; Pasqual, M.; Valente, T.C.T.; Oliveira, A.C.L.; Silveira, N.M. Análise bioquímica de calos de pinhão-manso. Ciênc. Rural. 2010, 40, 2268–2273. [Google Scholar] [CrossRef]
- Martin, A.B.; Cuadrado, Y.; Guerra, H.; Gallego, P.; Hita, O.; Martin, L.; Dorado, A.; Villalobos, N. Differences in the contents of total sugars, reducing sugars, starch and sucrose in embryogenic and non-embryogenic calli from Medicago arborea L. Plant Sci. 2000, 154, 143–151. [Google Scholar] [CrossRef]
- Chagas, E.A.; Pasqual, M.; Ramos, J.D.; Cardoso, P.; Cazetta, J.O.; Figueiredo, M.A. Development of globular embryos from the hybridization between ‘Pêra Rio’ sweet orange and ‘Poncã’ mandarin. Rev. Bras. Frutic. 2003, 25, 483–488. [Google Scholar] [CrossRef]
- Moscatiello, R.; Baldan, B.; Navazio, L. Plant cell suspension cultures. In Plant Mineral Nutrients: Methods and Protocols; Maathuis, F.J.M., Ed.; Humana Press: New York, NY, USA, 2013; pp. 77–93. [Google Scholar] [CrossRef]
- Nogueira, R.C.; Paiva, R.; Oliveira, L.M.; Soares, G.A.; Soares, F.P.; Castro, A.H.F.; Paiva, P.D.O. Indução de calos em explantes foliares de murici-pequeno (Byrsonima intermedia A. Juss.). Ciência Agrotecnologia 2007, 31, 366–370. [Google Scholar] [CrossRef][Green Version]
- Santos, C.G.; Paiva, R.; Paiva, P.D.O.; Paiva, E. Indução e análise bioquímica de calos em segmentos foliares e nodais de Coffea canephora L. cv. Apoatã. Magistra 2008, 20, 22–29. [Google Scholar]
- Nogueira, R.C.; Paiva, R.; Lima, E.C.; Soares, G.A.; Oliveira, L.M.; Santos, B.R.; Emrich, E.B.; Castro, A.H.F. Curva de crescimento e análises bioquímicas de calos de murici-pequeno (Byrsonima intermedia A. Juss.). Rev. Bras. Plantas Med. 2008, 10, 44–48. [Google Scholar]
- Silva, T.S.; Carvalho Filho, R.S.L.; Tanan, T.T.; Rocha, T.C.; Santana, J.R.F. Calogênese em Myracrodruon urundeuva Fr. All. Ciência Florest. 2020, 30, 700–717. [Google Scholar] [CrossRef]
- Silveira, V.; Floh, E.I.S.; Handro, W.; Guerra, M.P. Effect of plant growth regulators on the cellular growth and levels of intracellular protein, starch and polyamines in embryogenic suspension cultures of Pinus taeda. Plant Cell Tissue Organ Cult. 2004, 76, 53–60. [Google Scholar] [CrossRef]
- Queisser, M.A.; Yao, D.; Geisler, S.; Hammes, H.P.; Lochnit, G.; Schleicher, E.D.; Brownlee, M.; Preissner, K.T. Hyperglycemia impairs proteasome function by methylglyoxal. Diabetes 2010, 59, 670–678. [Google Scholar] [CrossRef]
- Mehta, B.M.; Deeth, H.C. Blocked lysine in dairy products: Formation, occurrence, analysis, and nutritional implications. comprehensive reviews in food. Compr. Rev. Food Sci. Food Saf. 2016, 15, 206–218. [Google Scholar] [CrossRef]
- Kandarakis, S.A.; Piperi, C.; Topouzis, F.; Papavassiliou, A.G. Emerging role of advanced glycation end products (AGEs) in thepathobiology of eye diseases. Prog. Retin. Eye Res. 2014, 42, 85–102. [Google Scholar] [CrossRef]
- Oliveira, F.C. Food protein-polysaccharide conjugates obtained via the Maillard reaction: A review. Crit. Rev. Food Sci. Nutr. 2016, 56, 1108–1125. [Google Scholar] [CrossRef]
- Purlis, E. Browning development in bakery products—A review. J. Food Eng. 2010, 99, 239–249. [Google Scholar] [CrossRef]
- Su, Y.; Liu, Y.; Zhou, C.; Li, X.; Zhang, X. The microRNA167 controls somatic embryogenesis in Arabidopsis through regulating its target genes ARF6 and ARF8. Plant Cell Tissue Org Cult. 2015, 124, 405–417. [Google Scholar] [CrossRef]
- Alwael, H.A.; Naik, P.M.; Al-Khayri, J.M. Synchronization of somatic embryogenesis in date palm suspension culture using abscisic acid. In Biotechnology Protocols, Date Palm; Al-Khayri, J.M., Jain, S.M., Johnson, D.V., Eds.; Springer: New York, NY, USA, 2017; Volume 1, pp. 215–226. [Google Scholar] [CrossRef]

| Lineages Cultivated | Fresh Mass (g) and Growing Period (Days) | ||||
|---|---|---|---|---|---|
| 60 | 90 | 120 | 150 | 180 | |
| L1 | 1.52 AB c | 1.75 AB bc | 1.811 BCD abc | 1.93 CDE ab | 2.19 BC a |
| L2 | 1.63 A c | 1.86 AB bc | 2.02 AB abc | 2.18 ABC ab | 2.35 AB a |
| L3 | 1.38 ABC bc | 1.54 BC ab | 1.62 CD ab | 1.70 DE ab | 1.91 BD a |
| L4 | 1.13 BC c | 1.71 AB b | 1.93 ABC ab | 2.06 BCD ab | 2.14 BC a |
| L5 | 1.14 BC cd | 1.24 C bcd | 1.42 D abc | 1.56 E ab | 1.67 D a |
| L6 | 1.69 A c | 2.00 A bc | 2.26A ab | 2.46 A a | 2.66 A a |
| L7 | 1.06 C d | 1.59 BC c | 1.98 ABC bc | 2.34 AB ab | 2.40 AB a |
| L8 | 1.08 C c | 1.78 AB b | 2.04 AB b | 2.16 ABC ab | 2.46 AB a |
| Parameters | Lineages | |||||||
|---|---|---|---|---|---|---|---|---|
| L1 | L2 | L3 | L4 | L5 | L6 | L7 | L8 | |
| a | 2.552 | 2.672 | 2.328 | 2.405 | 2.04 | 3.235 | 3.18 | 2.911 |
| b | −0.09 | −0.031000 | −0.1899 | 0.51238 | 0.008210 | 0.1559 | 0.69143 | 0.626376 |
| c | 0.00902 | 0.01084 | 0.00732 | 0.01599 | 0.019654 | 0.00988 | 0.01169 | 0.01326 |
| R2 (%) | 0.97 | 0.99 | 0.98 | 0.98 | 0.99 | 0.99 | 0.98 | 0.97 |
| Parameters | Lineages | |||||||
|---|---|---|---|---|---|---|---|---|
| L1 | L2 | L3 | L4 | L5 | L6 | L7 | L8 | |
| μmax (d−1) | 0.0229 | 0.0289 | 0.0169 | 0.0383 | 0.0102 | 0.0319 | 0.0371 | 0.0388 |
| λ (dia) | −120.878 | −95.0695 | −162.516 | −30.5 | −180.72 | −85.4472 | −26.4019 | −28.1818 |
| G (dia) | 30.1 | 23.9 | 40.8 | 18.0 | 53.6 | 21.7 | 18.6 | 17.9 |
Disclaimer/Publisher’s Note: The statements, opinions and data contained in all publications are solely those of the individual author(s) and contributor(s) and not of MDPI and/or the editor(s). MDPI and/or the editor(s) disclaim responsibility for any injury to people or property resulting from any ideas, methods, instructions or products referred to in the content. |
© 2024 by the authors. Licensee MDPI, Basel, Switzerland. This article is an open access article distributed under the terms and conditions of the Creative Commons Attribution (CC BY) license (https://creativecommons.org/licenses/by/4.0/).
Share and Cite
Vasconcelos, A.D.M.; Ferreira, J.C.B.; Meira, R.O.; Silva-Cardoso, I.M.d.A.; Neves, J.d.S.; Souza, A.M.d.; Souza, A.L.X.d.; Scherwinski-Pereira, J.E. Establishment, Multiplication, and Biochemical Analysis of Embryogenic Lines of the Amazonian Palm Euterpe precatoria Mart. under Suspension Culture. Forests 2024, 15, 1804. https://doi.org/10.3390/f15101804
Vasconcelos ADM, Ferreira JCB, Meira RO, Silva-Cardoso IMdA, Neves JdS, Souza AMd, Souza ALXd, Scherwinski-Pereira JE. Establishment, Multiplication, and Biochemical Analysis of Embryogenic Lines of the Amazonian Palm Euterpe precatoria Mart. under Suspension Culture. Forests. 2024; 15(10):1804. https://doi.org/10.3390/f15101804
Chicago/Turabian StyleVasconcelos, Alexandro Dias Martins, Jéssica Cristina Barbosa Ferreira, Rennan Oliveira Meira, Inaê Mariê de Araújo Silva-Cardoso, Joane dos Santos Neves, Anderson Marcos de Souza, André Luís Xavier de Souza, and Jonny Everson Scherwinski-Pereira. 2024. "Establishment, Multiplication, and Biochemical Analysis of Embryogenic Lines of the Amazonian Palm Euterpe precatoria Mart. under Suspension Culture" Forests 15, no. 10: 1804. https://doi.org/10.3390/f15101804
APA StyleVasconcelos, A. D. M., Ferreira, J. C. B., Meira, R. O., Silva-Cardoso, I. M. d. A., Neves, J. d. S., Souza, A. M. d., Souza, A. L. X. d., & Scherwinski-Pereira, J. E. (2024). Establishment, Multiplication, and Biochemical Analysis of Embryogenic Lines of the Amazonian Palm Euterpe precatoria Mart. under Suspension Culture. Forests, 15(10), 1804. https://doi.org/10.3390/f15101804

